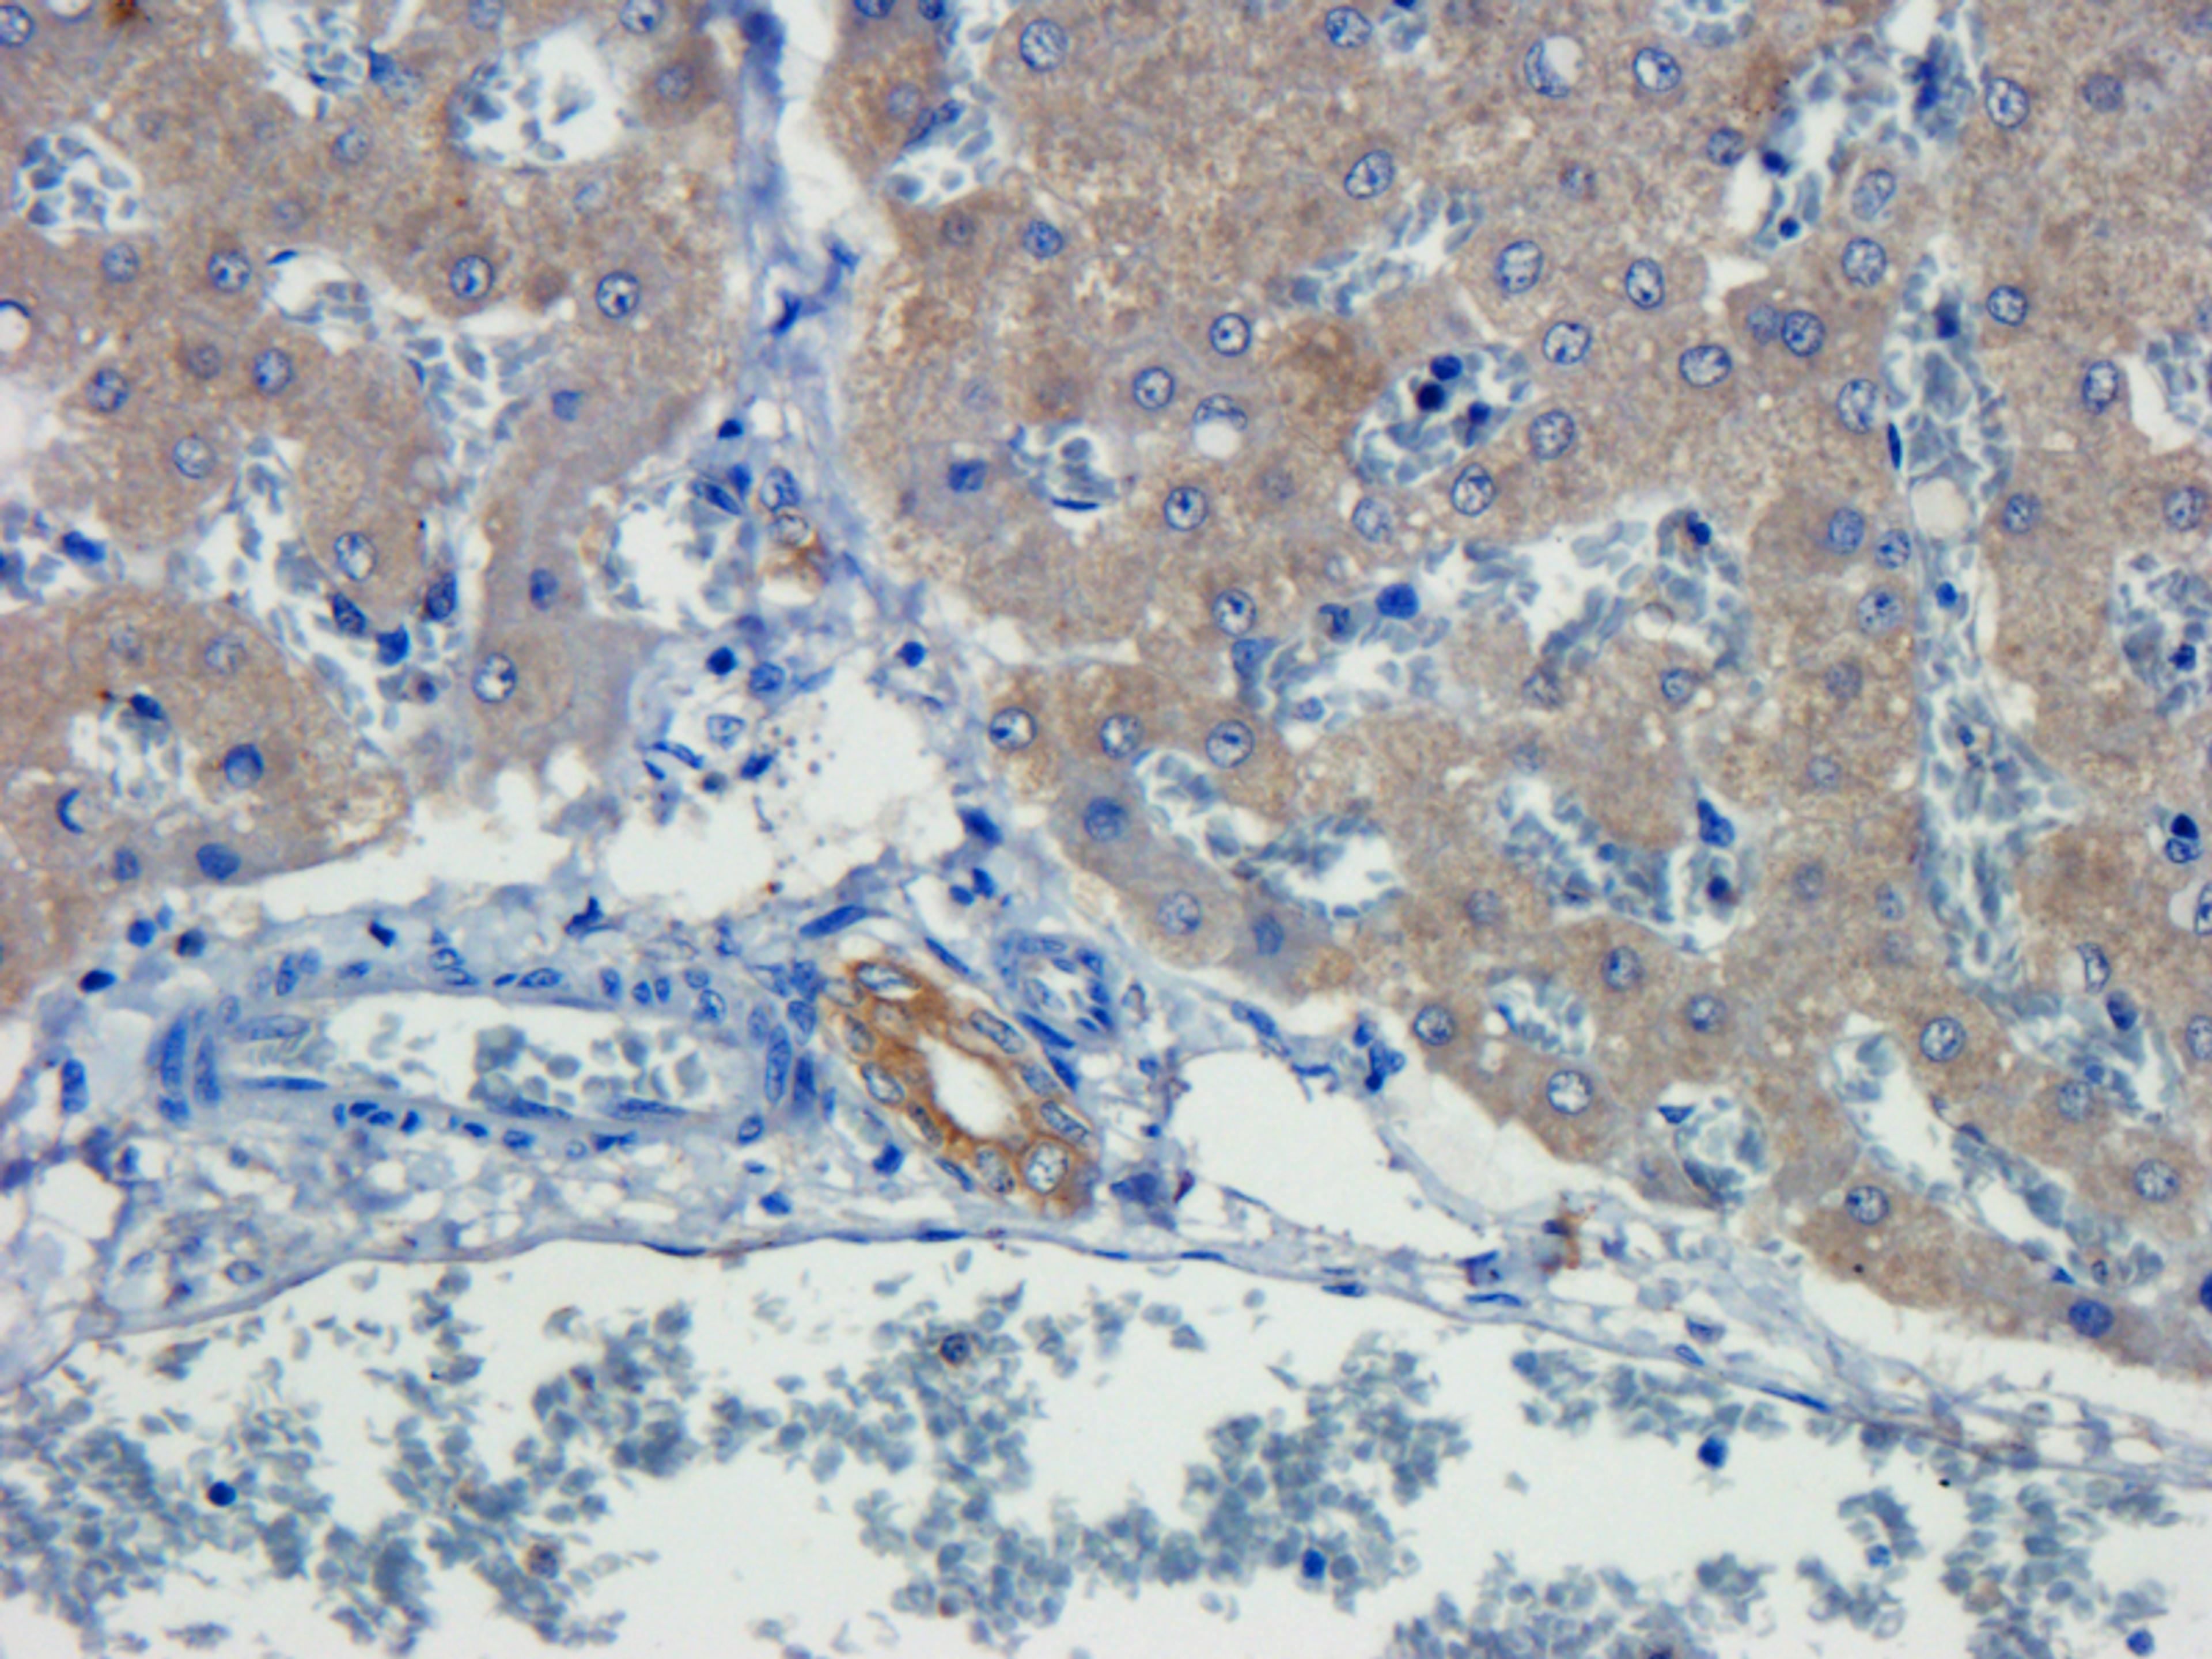
IHC-P staining of pig liver tissue using TNF alpha antibody (dilution at 1:100)

TNF alpha antibody
Product Details
- Cat. No.
- orb11495
- Type
- Primary Antibody
- Clonality
- Polyclonal
- Host
- Rabbit

The supplier does not provide quotations for this antibody through SelectScience. You can search for similar antibodies in our Antibody Directory.
Description
TNF (Tumor Necrosis Factor) is a Protein Coding gene. Diseases associated with TNF include Migraine With Or Without Aura 1 and Asthma. GO annotations related to this gene include identical protein binding and cytokine activity.Cytokine that binds to TNFRSF1A/TNFR1 and TNFRSF1B/TNFBR. It is mainly secreted by macrophages and can induce cell death of certain tumor cell lines. It is potent pyrogen causing fever by direct action or by stimulation of interleukin-1 secretion and is implicated in the induction of cachexia; Under certain conditions it can stimulate cell proliferation and induce cell differentiation.
Biological Information
- Clonality: Polyclonal
- Host: Rabbit
- Reactivity: Human, Mouse, Pig (Swine), Rat
- Clone: NULL
- Conjugate: Unconjugated
- Isotype: IgG
- Gene: 7124
Handling
- Quantity: 100 ?g
- Storage: Store at 4°C for up to two weeks. For long term storage; aliquot and store at -20°C; avoid freeze/thaw cycles.
- Buffer: 10 mM PBS; 0.02% sodium azide
Applications
- ELISA (ELISA)
- Immunofluorescence (IF)
- Immunohistochemistry (Paraffin-Embedded Sections) (IHC (P))